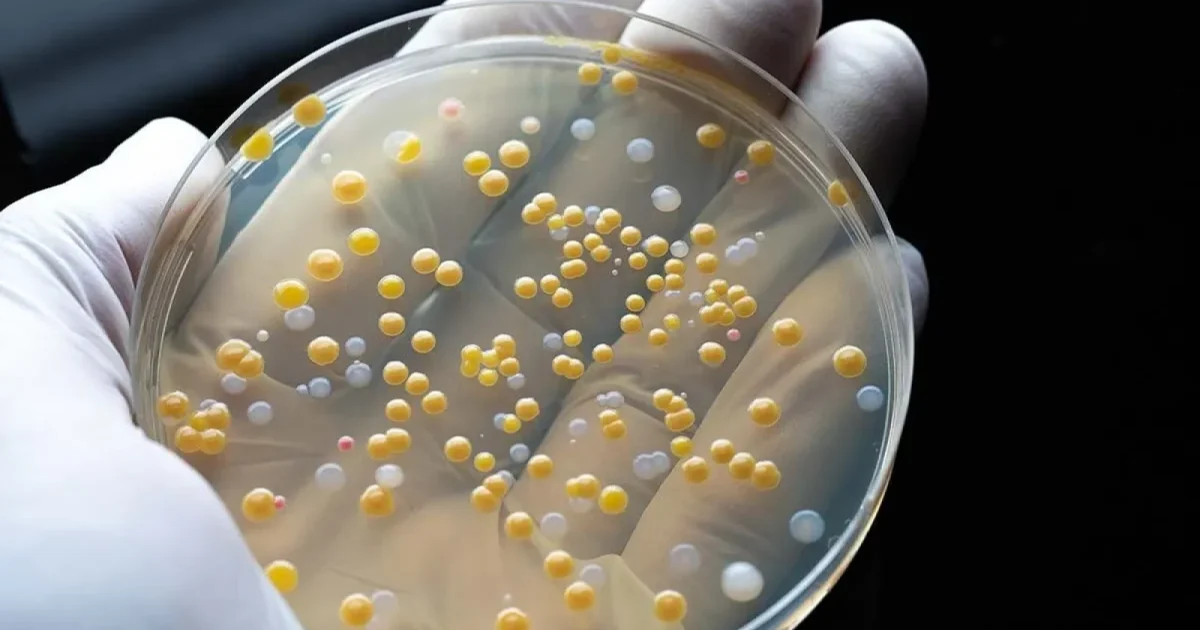
Dragostea și… Bacteriile: Cum împart cuplurile microbii!

Dragostea și… Bacteriile: Cum împart cuplurile microbii!

Zicala „Dragostea trece prin stomac” pare să fie mai înțeleaptă decât se credea inițial. În spatele acestui proverb tradițional, care se referă de obicei la mâncare, se ascunde un adevăr științific surprinzător. Partenerii de viață împart mult mai mult decât o simplă locuință. Cercetătorii au descoperit că persoanele care trăiesc împreună ajung să aibă în comun o proporție semnificativă din bacteriile intestinale.
Cum influențează conviețuirea microbiomul
Microbiomul uman reprezintă o comunitate complexă de bacterii, viruși și ciuperci care trăiesc în și pe corpul nostru. Printre acestea se numără și bacteriile intestinale, esențiale pentru sănătate. Acesta se formează încă din primii ani de viață, iar interacțiunile sociale cu cei din jur îl modelează continuu. Influența celor cu care conviețuim se manifestă direct asupra compoziției microbiotei noastre.
Cuplurile care locuiesc sub același acoperiș prezintă o diversitate microbiană mai mare comparativ cu persoanele care locuiesc separat. Această constatare este considerată benefică pentru sănătate. O microbiotă intestinală diversă poate reduce riscul de sindrom al intestinului iritabil, alături de posibilitatea de a diminua problemele cardiovasculare. De asemenea, poate avea efecte pozitive asupra controlului nivelului de zahăr în sânge.
Sărutul, un schimb de bacterii
Microbiomul oral este cel mai vizibil afectat de viața în cuplu. Partenerii se implică în schimburi regulate de salivă, iar un sărut de doar zece secunde poate transfera până la 80 de milioane de bacterii. Un microbiom oral sănătos contribuie la protecția împotriva cariilor dentare și are proprietăți antiinflamatorii. Există, totuși, și un risc – anumite bacterii pot fi dăunătoare și pot provoca infecții.
Efectul conviețuirii asupra microbiomului pielii este de asemenea notabil. Cercetătorii au reușit să identifice cu precizie, pe baza probelor bacteriene individuale, până la 86% dintre cuplurile care locuiesc împreună. Această predicție a fost realizată exclusiv pe baza bacteriilor prezente pe piele.
Efecte pozitive pentru sănătate
Concluzia cercetătorilor este încurajatoare. Schimbul de microorganisme între parteneri este un proces natural, cu efecte preponderent pozitive asupra sănătății ambilor. Deși poate părea alarmant la prima vedere, în majoritatea cazurilor nu există motive de îngrijorare.
Studiile au arătat că conviețuirea are un impact profund asupra microbilor intestinali și orali, cu consecințe directe asupra stării generale de sănătate. Aceste descoperiri subliniază importanța interacțiunilor sociale în menținerea echilibrului microbian.
Sursa: Stiripesurse.ro



